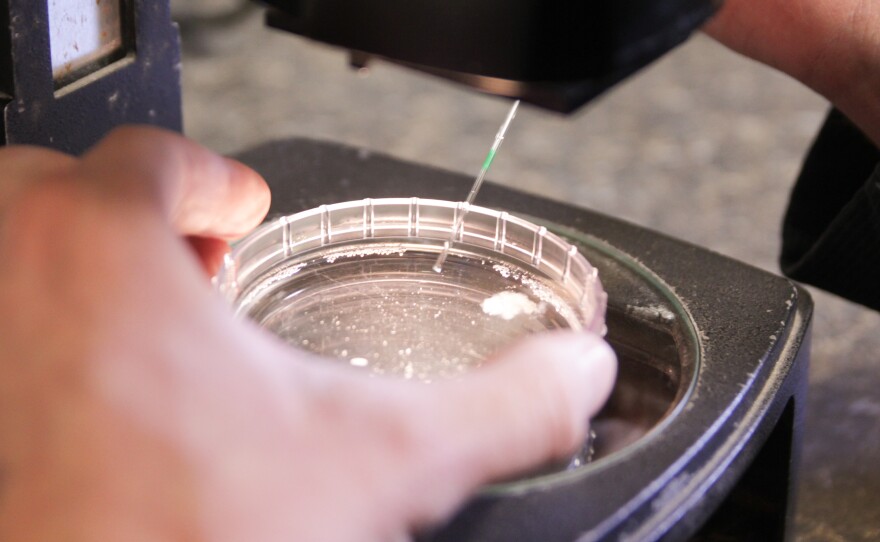

Panda, standing six feet tall and weighing almost a ton, is everything a show cow should be: broad-backed and round-rumped, with sturdy legs holding up her heft. Her hide — thick and black, with splotches of creamy white — fits her name.
"She's a big-time cow," says Dan Byers, owner of Byers Premium Cattle, Inc. "She's a freak of nature is what she is."
Because of her impeccable physique, Panda's descendants sell for a high price. Byers, an elite-cattle breeder in Roseville, Ill., owns several of Panda's daughters. He sold one of her grand calves last year for $10,000 to a family in Oklahoma that shows cattle at state fairs and national competitions.
Cows, like humans, take about nine months to carry a calf to term. At 8 years old, Panda should have seven calves. But in the 1970s, American cattlemen began bucking the reins of nature's limitations by performing a procedure called embryo transfer, or ET, as it's referred to in the industry.
Now, elite-cattle breeders and commercial beef and dairy producers use ET to reproduce dozens of calves a year from their genetically superior heifers, who never actually have to birth a single calf. Surrogates carry the embryos to term.
The process can be time consuming and costly. But Byers, who has bred his genetically superior cattle this way for six years, says it can pay off in the long run.
"There's definitely a lot of work that goes into it, compared to just raising them normally," Byers says. "But ultimately, when the cattle are good, then it should hopefully be more for your bottom dollar."
'You Just Reach Into A Cow And Do What You Got To Do'
Embryo transfer, which maximizes the number of offspring a female can reproduce, was first successfully reported in rabbits in 1890. Walter Heape, a pioneer in reproductive biology from England, collected embryos from a black rabbit and inserted them into a white rabbit. A month later, the white rabbit gave birth to a litter of black bunnies. The first ET calf, born in Wisconsin, came along in 1951.
ET entails several steps. First, the cow's owner injects her with a series of hormones, so she'll produce multiple eggs.
Next, she's bred by a choice stud bull — either the old-fashioned way or, more typically, through in-vitro fertilization. The fertilized eggs, or embryos, are complete genetic packages carrying the bull and dame cow's traits.
Normally, a cow would only carry a single embryo at a time. However, cows that undergo ET hormone therapy typically produce about six or seven usable embryos — though some can produce as many as 80 or 90 embryos at once.
Then, a livestock vet performs the "embryo flush," the procedure used to get all those invisible genetic packages out.
On a windy afternoon, Dr. Michael Pugh, owner of Westwood Embryo Services, turns Panda's cattle barn in rural Illinois into an impromptu laboratory. Petri dishes and microscopes line the workbench; boxes of needles and catheters crowd the floor. Pugh is stationed at Panda's rear, donning boots, overalls, and a plastic glove up to his shoulder. He sticks Panda with an epidural, then slides his entire arm inside.
"It seems so routine to me now — when you just reach in a cow and do what you got to do," Pugh chuckles. "And she's kind of an old pro. She just walked in here and stood."
Pugh massages saline solution around Panda's uterus, helping the embryos release from her ovaries and slip through a catheter into a receptacle slightly fancier than a Dixie cup. He peers through a microscope into the fluid and counts them, ranking embryos from the highest grade, "transferable," to the lowest, "degenerates."
"The best part, for me, is when you go look at the embryos in a dish and you realize, no. 1, what their value is for the client," Pugh says. "And then that, you know, those are calves right there."
Panda produced six for six good embryos that Pugh seals in glass straws and freezes in tanks of liquid nitrogen. They take a short trip down the road to a second barn, where they're inserted into less valuable, "surrogate mother" cows who will carry them to birth.
ET is one of several reproductive technologies ranchers use to manage the genetics of their herd. Artificial insemination and in vitro fertilization are common practices, in addition to being able to select for the sex of the calf and test an embryo's DNA for undesirable traits or diseases.
When using ET, there is the risk of inbreeding. If ranchers choose to breed only offspring from a single cow, they can limit the herd's genetic diversity, potentially making them more vulnerable to disease.
"I think we have to be careful about how far we push the envelope," Pugh says.
Paradoxically, ET can also help preserve genetic diversity. As Harvest Public Media's Luke Runyon has reported, the USDA stockpiles embryos from a wide variety of livestock breeds in Fort Collins, Colo.
The Embryo Export Industry
U.S. beef and dairy genetics are in-demand all over the world.
Producers use ET to collect and export embryos globally: Full-bred beef embryos fly to Australia and Brazil; high-end dairy embryos voyage to Japan and China. In-country, they're implanted in local surrogates and born not to produce hamburgers and milkshakes, but to become the matriarchs and patriarchs of a burgeoning cattle industry.
"You don't want to eat them," says Matthew Wheeler, a professor of animal sciences at the University of Illinois. "They're too valuable."
The U.S. is currently the leader in cattle embryo exports, shipping off about 15,000 embryos a year, according to the American Embryo Transfer Association, the trade group that certifies and tracks ET procedures. The AETA's numbers are a rough estimate, given that embryo-transfer service providers voluntarily submit data on an annual basis, and many businesses resist sharing information for fear competitors will encroach on their market.
Wheeler, who's been involved in the embryo business since the 1970s, says U.S. genetics are a hot commodity — the cream of the crop have sold for a half-million bucks — because American cows are milk and meat production machines.
"You can just look at U.S. dairy cattle and see how much more they're producing," Wheeler says.
America's Angus cattle gain more beef per pound of animal, and U.S. Holsteins can out-milk pretty much any cow on Earth. That's partly because the U.S. has lots of land, water and feed. But Wheeler says it's also because we've bred them that way for over a century.
And the U.S. herd is getting more efficient all the time. According to Wheeler, since 1940, producers have decreased the number of dairy cattle by half, while increasing milk production by 2.5 times. He says other countries are eager to tap into our successful gene pool.
"We're not pushing our genetics on them," he says. "They're coming to us."
Helping Countries That Don't Produce Enough Milk
While America still ships whole animals overseas, it's easier to load a bunch of embryos on a 747 than it is to pack up a herd. Embryos are also less susceptible to disease than cows, because they spend nine months in a native cow's womb, soaking up her antibodies and developing an immune system suited to the local environment.
Wheeler, who used to be in the business of selling high-end genetics, is now working with his lab at the University of Illinois to develop a decent, low-cost embryo for countries who struggle to produce enough milk. The lab has partnerships with scientists, cattle producers, and ministers of agriculture in several countries, including Sri Lanka, Thailand, the Dominican Republic, Panama, Sierra Leone, Libya and Rwanda.
"Rwanda ... had a civil war where many of the cattle were also killed in the genocide," Wheeler says. "So they're interested in redeveloping their cattle herd, and they want to do it with better genetics."
Many of these countries sit along the Earth's tropical belt, a climate too hot for full-bred Angus and Holsteins. The embryos Wheeler ships are typically cross-bred with Bos indicus breeds, cows that are native to these countries. Bos indicus cattle have a hump on their back, floppy ears and flabby necks to help keep the flies off and release extra heat.
Wheeler says sometimes local farmers hesitate to adopt the technology.
"They're farmers, so they're skeptical," he says. "But the farmers that have animals old enough to milk and they're producing more milk and getting more money in their pocket, they're really enthusiastic to have us come back."
A Surrogate Gives Birth
Back at Dan Byers' farm in western Illinois, expectant cows pace around the pasture. Right now, 140 of them are pregnant, the majority with embryos from a handful of donors.
Looking out over the field, Byers spots surrogate mother No. 4030 clearly getting ready to give birth.
"You can tell by the way she's pacing that something's going on with her," he says.
On this occasion, the embryo calf is coming out backwards, so Byers calls the vet. The men use a crank to try and muscle the calf out. The cow's knees buckle with pain. After a few more attempts, they opt for a C-section. The vet makes a large incision in her side, tugs, and the newborn calf slides out.
Byers carries her to a bed of straw, checks her heart beat, and sprinkles her with sweet molasses powder, which will help prompt her mother to lick her clean, a maternal instinct sometimes silenced by surgical birth.
If all goes according to Byers' plan, the ET calf will grow up to become another American show cow champion.
Abby Wendle reports from Illinois for Tri States Public Radio and Harvest Public Media, a public radio reporting collaboration that focuses on agriculture and food production issues. A version of this story originally appeared on Harvest Public Media's site.
Copyright 2015 Tri States Public Radio. To see more, visit http://www.tristatesradio.com.